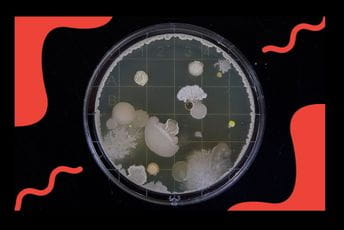
Novi načini učenja biologije Novi načini učenja biologije

Mali broj djece će kao odgovor na pitanje koji im je omiljeni predmet reći fizika, matematika ili biologija. Ipak, danas su najperspektivnijia zanimanja bazirana upravo na znanjima iz ovih oblasti, stoga bi trebalo da ih djeci predstavimo kao zanimljive nauke, nauke koje će im omogućiti da upoznaju svijet koji ih okružuje kroz istraživanje. Osnovcima ili srednjoškolcima knjiške definicije često zvuče previše apstraktno i daleko, pa bi naš glavni zadatak trebalo da bude da im na što jednostavniji I zanimljiviji način objasnimo što se to dešava u prirodi koja nas okružuje.
Kada govorimo o biologiji, iako je nekada vladalo mišljenje da biolozi često ne mogu naći drugi posao osim nastavnika i profesora u školi, pomislimo samo na sve probleme sa pandemijom virusa korona ili globalne probleme o kojima se stalno govori - zagađenost vazduha, globalno zagrijavanje, manjak zelenih površina… Dakle, stručnjaci iz oblasti biologije, mikrobiologije i ekologije su nam neophodni.

Alati koji podstiču kreativnost kod djece
Djeca od najranijeg perioda imaju one faze kada znaju do beskonačnosti, na svaku tvoju konstataciju, da pitaju: “Zašto?”. Iako smo nekada u žurbi ili nam nešto drugo izgleda hitnije, moramo znati da istraživače u našoj djeci gradimo baš mi - roditelji, i to od malena. Kasnije, u školi, oni samo prate put koji smo im pokazali, a početak svakog novog saznanja počeće im onda kada sebi ili drugima postave poznato pitanje: “Zašto?”.
U kompaniji doMEn, kao svoje poslovno okruženje, na sličan način svakodnevno istražujemo Internet. Jednog dana, naišli smo na članak o instrumentima koje su napravili studenti sa Stanford Univerziteta - Manu i Jim. Oni su osmisli novi način uvećavanja nevidljivih stvari: izuzetno skupe i rogobatne mikroskope, koje većina škola ne može obezbijediti u dovoljnom broju, zamijenili su malim, papirnim, ali otpornim optičkim instrumentima koji mogu uvećati pojave koje se posmatraju od 20 do 1400 puta. Inspiraciju za ovakav izum našli su upravo u rodnoj Indiji, gdje osim u školama, ovaj instrument koriste za ispitivanje pijaće vode i prisustvo mikroorganizama.
U članku je pisalo da danas ove instrumente koristi preko milion ljudi u svijetu, pa smo se nakon čitanja zapitali zašto i djeca u Crnoj Gori ne bi imala ovakva pomagala u svojim školama.

Foldoskopi po prvi put u cetinjskoj gimnaziji
Tako smo prošle školske godine gimnazijalce sa Cetinja obradovali foldoskopima koji su ih na početku, kada nisu znali baš o čemu se radi, podsjećali na origami i nešto sa čim će se igrati u narednom periodu. Ipak, od samog početka nije bilo straha da će ih polomiti i da je to skupocjenost koju iz prikrajka učionice mogu samo da gledaju, već su “zavrnuli rukave” i odmah se dali u sastavljanje svojih instrumenata.
Inače, kako kažu i iz kompanije Foldscope, sastavljanje foldoskopa učenike dodatno podstiče na logičko razmišljanje, zaključivanje, ali i timski rad, jer je potrebno vrlo precizno sklopiti foldoskop kako bi bio funkcionalan.
Kako je sve izgledalo nakon dobijanja foldoskopa:
Kako nam je posvjedočio i profesor cetinjske gimnazije Petar Špadijer, “mini mikroskopi” probudili su kreativnost i radoznalost kod njegovih učenika, pa su oni, kada su ih na kraju sastavili, na njihovo korišćenje gledali kao na nagradu za uloženi trud.
Profesor Petar kao glavnu prednost korišćenja foldoskopa u nastavi ističe njihovu laku prenosivost. Upravo zbog toga učionicu je prošle godine često zamjenjivao obližnjim parkom u kom su srednjoškolci ono o čemu uče, posmatrali instrumentima koje sami sastavljaju.
Jedan od učenika nam je poslao fotografije kako on vidi djelove pauka koristeći foldoskop, pa i ne čudi da je gimnazijalcima lekcija o insektima sada jedna od omiljenih.

Koristimo najnovije računare, sve bolje verzije telefona, slušalica, pametnih satova… Tehnologija napreduje. Hajde da našoj djeci omogućimo da uz pomoć novih tehnologija rastu i razvijaju svoju maštu i radoznalost u najboljem mogućem pravcu. Jer u nove tehnologije ne spadaju samo nova kamera ili novi telefon, već kao što vidiš, i školstvo može biti unaprijeđeno uz pomoć kreativnosti, a njihovu moć najbolje vidimo tokom pandemije virusa korona, kada nam omogućavaju da ostanemo u kontaktu i nastavimo sa redovnim aktivnostima i iz topline svog doma. Gradeći kreativnost kod naše djece, podržavajući ih i upoznajući sa svim benefitima novih tehnologija, zajedno gradimo bolju budućnost za sve nas.
Jesmo li i vas zainteresovali da istražite nove tehnologije u nastavi?
Ovaj članak dio je društveno odgovornog poslovanja kompanije DoMEn koja godinama ulaže napore da Internet i nove tehnologije približi crnogorskom društvu, a posebno mladima. Od svog osnivanja, donira i direkto učestvuje u projektima koji podržavaju i unapređuju crnogorsko školstvo. Prošle godine kompanija je pokrenula portal www.stemedukacija.me namijenjen popularizaciji prirodnih nauka među mladima.